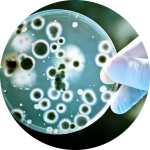
Стаття: Вплив ОЗОНУ на організм, бактерії і віруси. Стаття: Вплив ОЗОНУ на організм, бактерії і віруси.

Ваш кошик порожній
Бренды
- ZtDental
- JD Dental Implants
- SDI
- PREVEST DenPro
- ACEONEDENT
- ADM DENTAPREG
- AMD LASERS
- APOZA
- BIOVISION (Germany)
- BOMEDENT Endodontics
- DENTATUS
- DENTOFLEX
- DENTTIO
- DMP
- DuraMedical (Malaysia)
- DXM
- ERGON EST
- ESACROM
- FALCON
- HOYA ConBio
- HULASER
- FGM
- FORMLABS
- MEDAL
- MEDIC NRG
- MEDIPAC
- HEYDENT GmbH (Germany)
- MEGO AFEK
- PARMAX
- PERFECT
- PREMIUM PLUS
- PRIME-DENTAL Manufacturing
- PRITIDENTA
- PSP DENTAL
- SEILER
- SUPERMAX
- SYBRON ENDO
- UNICARE BIOMEDICAL
- VISTA Dental Products
- WILLMANN and PEIN
- Костная ткань (БКК)
- МЕДИМ
- СУЛЬФАКРИЛАТ
Новинки
Залежно від концентрації і способів введення озону розрізняють наступні ефекти:
1. Антибактеріаль..
Характерними хімічними властивостями озону в першу чергу слід вважати його нестійкість, здатність шв..
Медичний центр лікування онкологічних і хронічних
захворювань Академіка РАЕН Маленкова А.Г. (М.Моск..
C02 СURING LIGHT являє собою невеликий портативний акумулятор виробництва Premium Plus для щоденно..
EXPLORER HD віідеоскоп є унікальним приладом в своєму роді.
Цифрова відеокамера забезпечує чітке от..
НТКС-300-01 турбінний наконечник для терапевтичних робіт (Т):
кнопковий наконечник зі стандартною г..
НТС-300-05 турбінний наконечник для терапевтичних робіт (Т):
фрикційний наконечник зі стандартною г..
Gentlefile System позволяет проводить высококачественное эндодонтическое лечение.
..